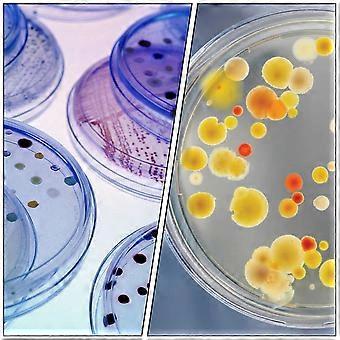
product image

20Pcs Transparent Petri Dishes Plastic Petri Dish for Laboratory Culture Yeast
INGYENES kiszállítás

20Pcs Transparent Petri Dishes Plastic Petri Dish for Laboratory Culture Yeast
- Márka: Unbranded
20Pcs Transparent Petri Dishes Plastic Petri Dish for Laboratory Culture Yeast
- Márka: Unbranded
Megtakarítás 24 900,00 Ft (79%)
RRP
Megtakarítás 24 900,00 Ft (79%)
RRP
A következő fizetési módokat fogadjuk el
Leírás
- Márka: Unbranded
- Kategória: Petri csészék
-
SzÃn: Transparent
-
Méret: 7.00X7.00X1.50CM
- Fruugo azonosító: 380942418-821365596
- EAN: 4053377359543
Termékbiztonsági információk
Kérjük, olvassa el a termékre vonatkozó biztonsági információkat az alábbiakban
Az alábbi információkat a terméket értékesítő független, harmadik fél kiskereskedő biztosítja.
Termékbiztonsági címkék

Kiszállítás és visszaküldés
Kiküldés 2 napon belül
-
STANDARD: INGYENES - közötti szállítás H 24 november 2025–H 01 december 2025 - INGYENES
Szállítás innen: Kína.
Minden tőlünk telhetőt megteszünk annak biztosítására, hogy rendelését hiánytalanul és előírásainknak megfelelően szállítás ki önnek. Viszont ha egy hiányos rendelést kap, vagy eltér a megrendelttől, vagy bármilyen más okból nem elégedett a rendeléssel, akkor visszaküldheti a rendelést vagy a rendelésben lévő bármely terméket, és visszatérítik a termék árának teljes összegét. Teljes visszaküldési irányelvek megtekintése.
Termékmegfelelőségi részletek
Kérjük, tekintse meg a termékre vonatkozó megfelelőségi információkat az alábbiakban.
Az alábbi információkat a terméket értékesítő független, harmadik fél kiskereskedő biztosítja.
Gyártó:
Az alábbiakban olvashatók a Fruugo platformján értékesített releváns termék gyártójának elérhetőségei.
- Shenzhen Dailidas Trading Co., Ltd.
- Shenzhen Dailidas Trading Co., Ltd.
- B7C1, 2nd Floor, ASEAN Building, No. 690 Minzhi Avenue, Xinniu Community, Minzhi Street, Longhua District, Shenzhen City
- Shenzhen
- CN
- 518000
- ythingful@outlook.com
- 19928320263
Felelős személy az EU-ban:
Az alábbiakban olvashatók az Európai Unióban kijelölt felelős személy elérhetőségei. A felelős személy az az Európai Unióban székhellyel rendelkező gazdasági társaság, amely az Európai Unióban eladott releváns termékekhez kapcsolódó megfelelőségi kötelezettségekért felel.
- EC REP SERVICES SL
- EC REP SERVICES SL
- Calle Gran Via 49, 7 Dch.
- Madrid
- ES
- 28013
- ecrepservice@hotmail.com
- 0034 910 5631 02